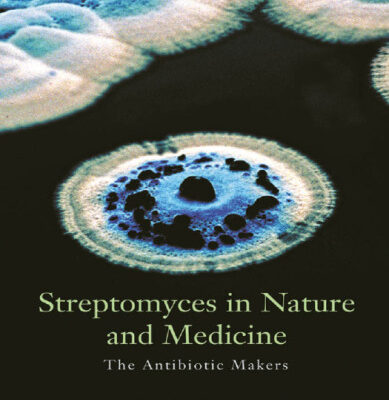

خرید و دانلود نسخه کامل کتاب Bugs Bunny - Party Pest 71,500 تومان قیمت اصلی 71,500 تومان بود.34,000 تومانقیمت فعلی 34,000 تومان است.
خرید و دانلود نسخه کامل کتاب Streptomyces in Nature and Medicine: The Antibiotic Makers 86,500 تومان قیمت اصلی 86,500 تومان بود.49,000 تومانقیمت فعلی 49,000 تومان است.
فقط اینقدر👇 دیگه زمان داری با تخفیف بخریش
00روز
16ساعت
26دقیقه
07ثانیه
خرید و دانلود نسخه کامل کتاب Morphometric Methods in Biostratigraphy
85,500 تومان قیمت اصلی 85,500 تومان بود.48,000 تومانقیمت فعلی 48,000 تومان است.
تعداد فروش: 75
| عنوان فارسی | روشهای ریخت سنجی در بیوگرافی نقشه برداری |
|---|---|
| عنوان اصلی | Morphometric Methods in Biostratigraphy |
| ناشر | |
| نویسنده | Richard A. Reyment |
| ISBN | 0125869800, 9780125869805 |
| سال نشر | 1980 |
| زبان | English |
| تعداد صفحات | 93 |
| دسته | بیوفیزیک |
| فرمت کتاب | pdf – قابل تبدیل به سایر فرمت ها |
| حجم فایل | 10 مگابایت |
1 آیتم فروخته شده در 55 دقیقه
4 نفر در حال مشاهده این محصول هستند!
Categories: بیوفیزیک, زیست شناسی



نقد و بررسیها
هنوز بررسیای ثبت نشده است.